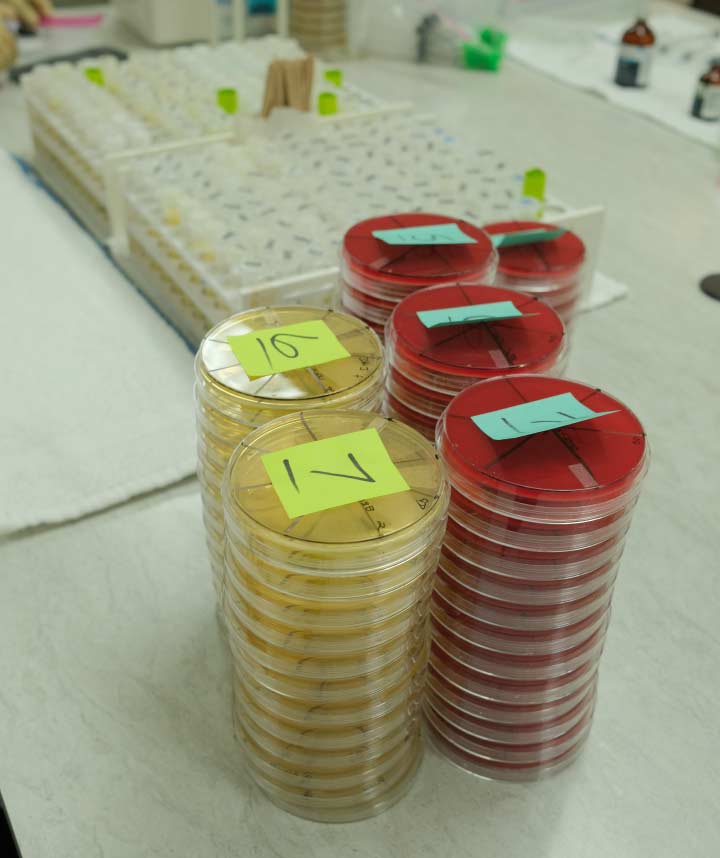
Milk Quality Laboratory

Dedicated Milk Quality Laboratory
Rapid, Targeted Mastitis Diagnostics
Protecting Your Milk Check and Herd Health
Mastitis is the single most costly disease for dairy producers. At Valley Veterinarians, our on-site Milk Quality Laboratory is a crucial part of our commitment to your profitability. We offer rapid, precise, and targeted diagnostic services that go beyond standard bulk tank monitoring.
By quickly identifying the specific bacterial pathogens causing mastitis in your herd, we empower you to implement targeted treatment protocols that reduce antibiotic use, minimize milk loss, and protect your milk quality premium.
Timely, More Accurate Diagnosis with Molecular Technology
Our laboratory services are enhanced with cutting-edge DairyGuard technology, utilizing Polymerase Chain Reaction (PCR), a sophisticated technique that amplifies DNA in milk samples. This DairyGuard platform allows for highly accurate and sensitive identification of even low levels of bacteria, including some difficult to detect with traditional plating methods.
Benefits for Your Dairy Operation:
- Enhanced Accuracy: DairyGuard provides a more comprehensive picture of the organisms present in your milk.
- Improved Sensitivity: The platform can detect even low levels of bacterial DNA that might be missed by plating
- Timely Results: DairyGuard offers comparable turnaround times compared to traditional methods, helping you address mastitis concerns promptly.





The Valley Veterinarians Diagnostic Advantage
Our laboratory services are integrated directly with our Herd Health and Dairy Records Analysis programs. We can upload results directly to your herd management software in addition to sending results via email and SMS messaging, ensuring that diagnostic results lead immediately to actionable management decisions.
Key services provided by our laboratory include:
- Individual and Bulk Tank Culturing: Fast and reliable culturing to identify the presence and concentration of mastitis-causing pathogens, including contagious and environmental organisms.
- Pathogen Identification: Precise identification of specific bacteria (e.g., Staphylococcus aureus, Streptococcus agalactiae, Coliforms) to guide the selection of the most effective, targeted treatment.
- Mycoplasma Testing: Specialized testing for Mycoplasma bovis, a highly contagious and costly pathogen, to isolate affected animals and prevent herd-wide spread.
- Advanced Diagnostics using PCR technology: Identify pathogens down to the molecular level, even in contaminated samples. Ideal for bulk tank and pen level screening.
- Web-Based Results Database: All your diagnostic results in one place. Log in to your individual account to view current and past results, track trends, and monitor herd-level incidence.
Turning Lab Results into Farm Protocols
Our laboratory doesn’t operate in a vacuum. Once results are available, our veterinarians work with you to implement strategic changes:
- Milking Protocol Refinement: Using laboratory data to identify procedural gaps in the milking parlor that may be contributing to the spread of mastitis.
- Dry Cow and Transition Management: Adjusting protocols based on pathogen profiles to reduce new infections during the critical dry period.
- Environmental Audits: Collaborating to assess bedding, ventilation, and sanitation, which are often sources of environmental mastitis pathogens.

Why Choose Valley Vets
Years of Local Expertise
Since 1970, we have been the trusted name in veterinary care, providing proven, reliable solutions tailored to the Central Valley’s agricultural community.
%
Dairy & Calf Ranch Focused
We specialize exclusively in dairy and calf ranch health, ensuring our 16 veterinarians possess deep, targeted knowledge for your operation’s unique needs.
Dedicated Veterinarians
Our large team ensures fast, reliable service and diverse, expert knowledge—meaning you always have access to the best care for your herd.
Ready to Partner With Us?
Contact us today to schedule a consultation and let's get started on a healthier future for your herd.

